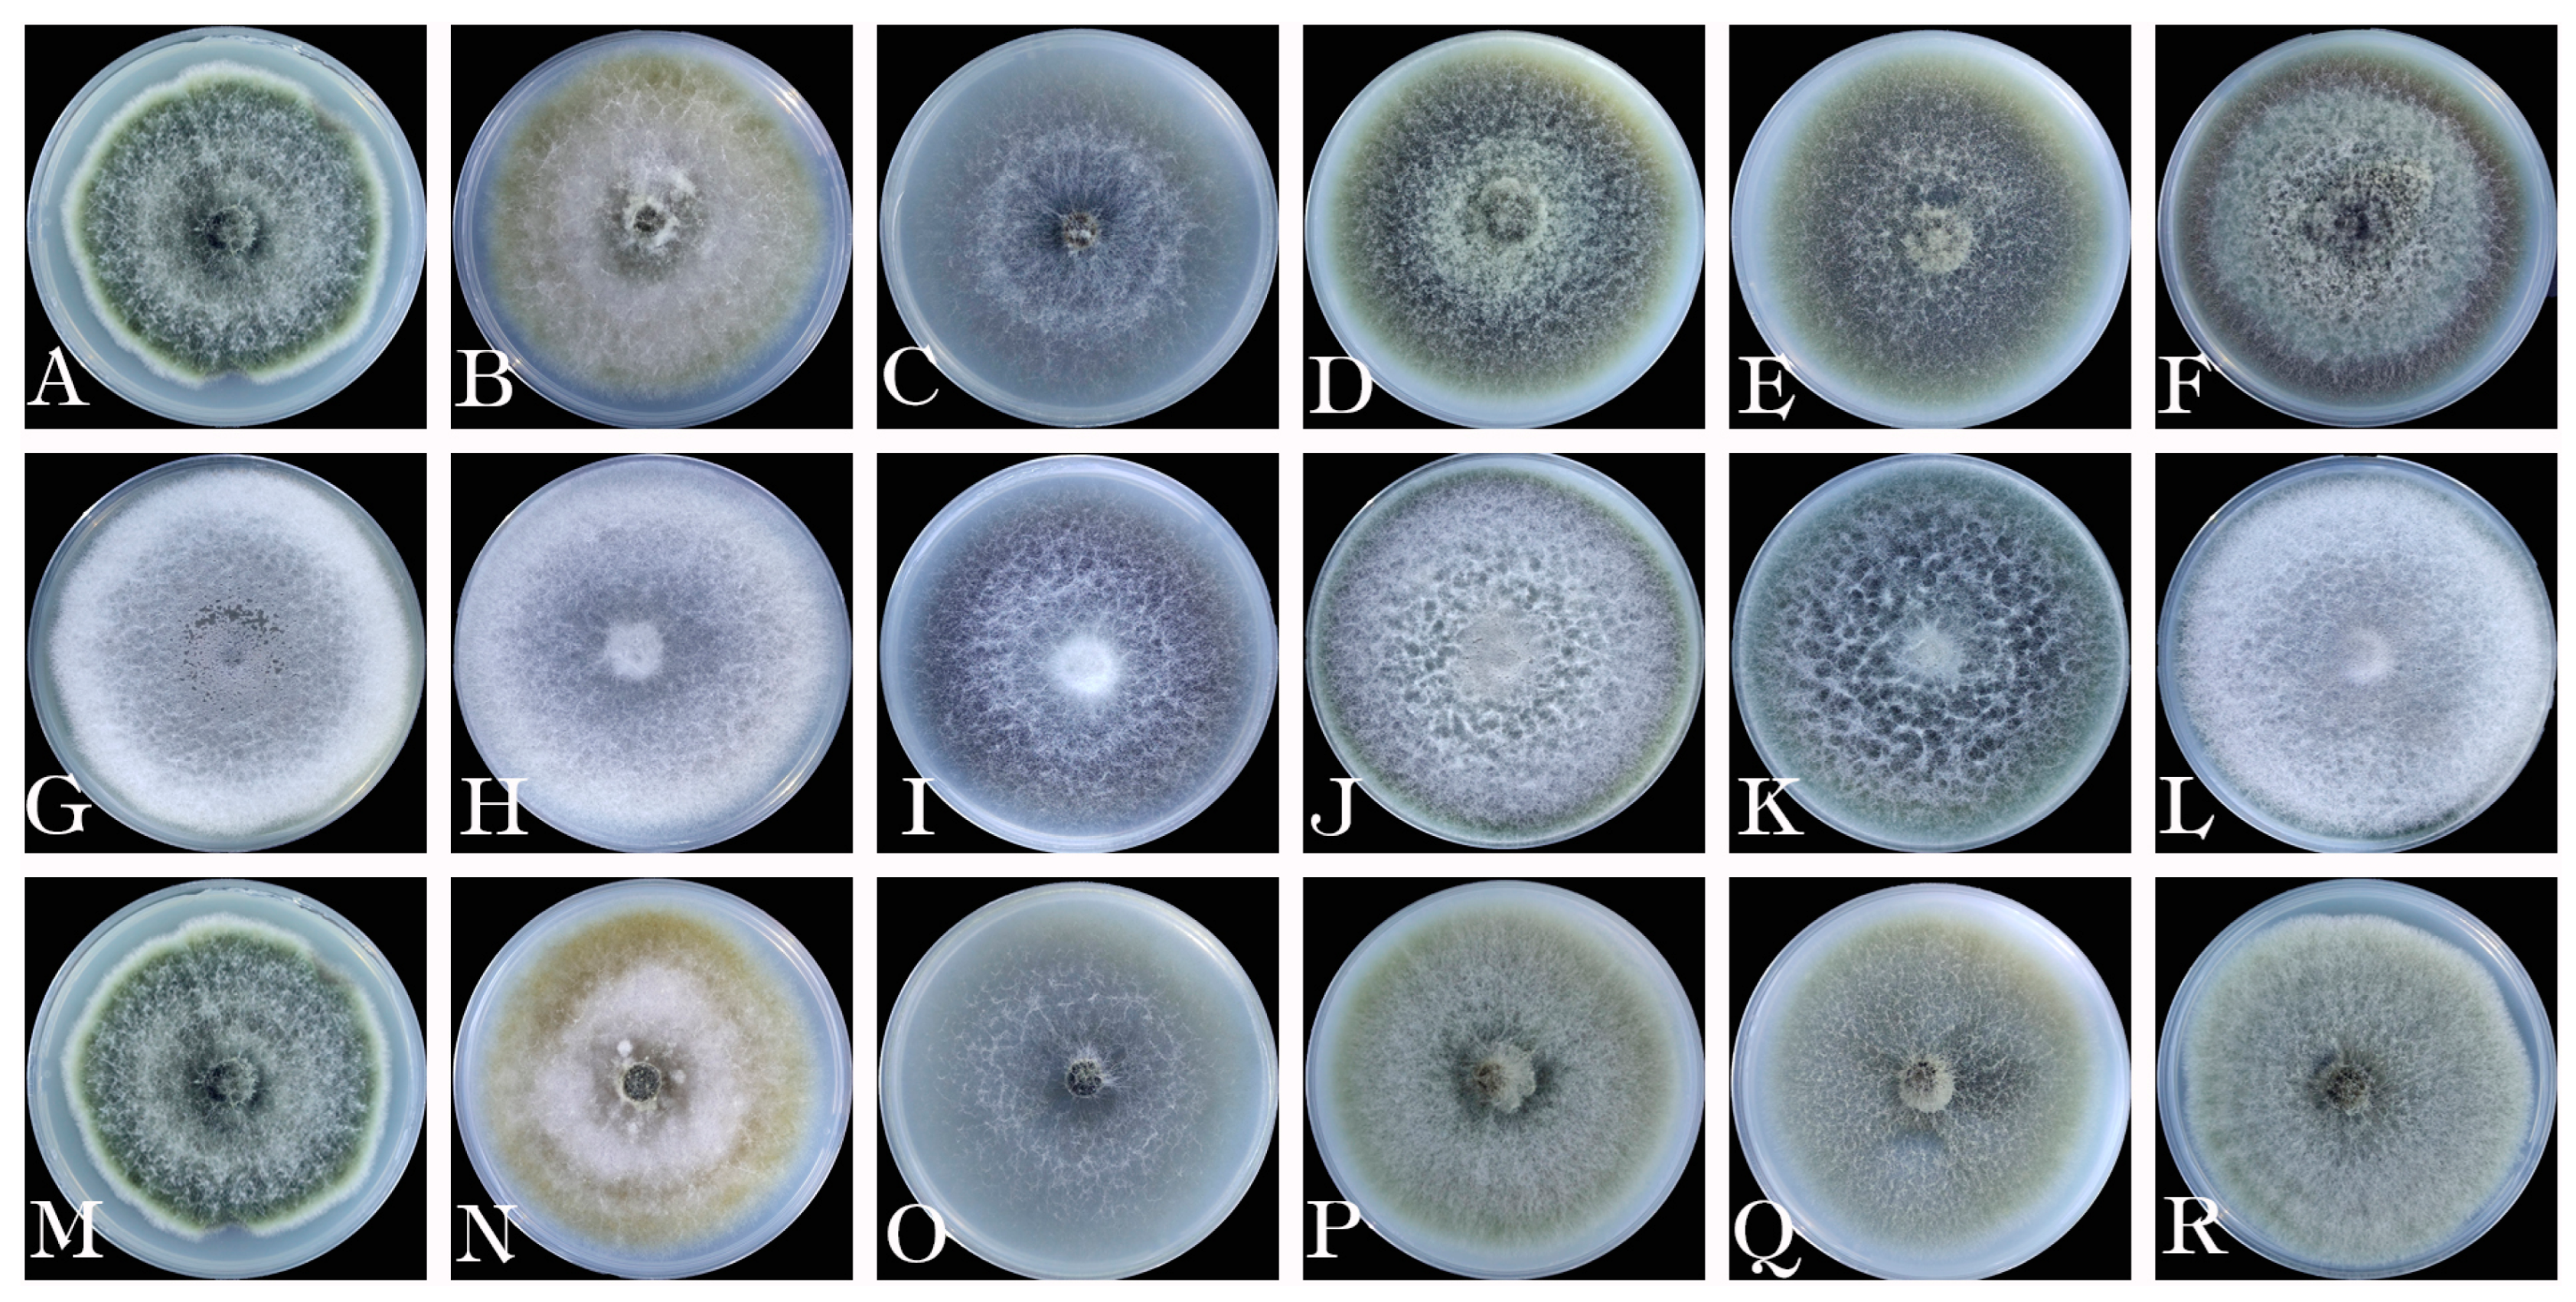

Alternaria alternata and Alternaria koreana, the Causal Agents of Leaf Spot in Celtis sinensis and Their Sensitivity to Fungicides
Abstract
:1. Introduction
2. Materials and Methods
2.1. Sampling and Fungal Isolations
2.2. Pathogenicity Tests
2.3. Morphological Identification and Biological Characteristics
2.4. DNA Extraction, PCR Amplification, and Sequencing
2.5. Phylogenetic Analyses
2.6. Evaluation of Fungicides against A. alternata (Isolates 11, 13) and A. koreana (Isolate 12)
3. Results
3.1. Field Observations and Fungal Isolation
3.2. Pathogenicity Test
3.3. Morphological Characteristics
3.4. Multigene Phylogenetic Analysis
3.5. Biological Characteristics
3.6. Susceptibility of Alternaria Isolates to Fungicides
4. Discussion
5. Conclusions
Author Contributions
Funding
Data Availability Statement
Acknowledgments
Conflicts of Interest
References
- Fan, J.; Chen, Y.; Luo, M.; Liang, Z.; Nong, X. The chloroplast genome characteristics, comparative genomics and gene resource mining of Celtis sinensis (Persoon, 1805). Mitochondrial DNA Part B 2022, 7, 698–704. [Google Scholar] [CrossRef] [PubMed]
- Lee, H.B.; Lee, K.H.; Nguyen, T.T.T. First Report of Powdery Mildew Caused by Erysiphe michikoae on Celtis sinensis in Korea. Plant Dis. 2020, 104, 984–985. [Google Scholar] [CrossRef]
- Guozheng, W.; Yunyan, Z.; Jiehan, Z.; Mengyuan, Z.; Yimin, H.; Yongjing, T.; Jingbo, Z.; Zhongsheng, W. Characterization of the first complete chloroplast genome sequence of Celtis sinensis (Cannabaceae) and its phylogenetic implications. Mitochondrial DNA Part B 2019, 4, 4091–4093. [Google Scholar]
- Huizheng, W.; Shilong, W.; Yubin, L. First Report of Botryosphaeria dothidea Causing Leaf Spot and Wilt on Celtis sinensis in China. Plant Dis. 2021, 105, 217. [Google Scholar]
- Liang, L.; Li, H.; Zhou, L.F.; Chen, F.M. Lasiodiplodia pseudotheobromae causes stem canker of Chinese hackberry in China. J. For. Res. 2020, 31, 2571–2580. [Google Scholar] [CrossRef]
- Liao, Y.C.Z.; Cao, Y.J.; Wan, Y.; Li, H.; Li, D.W.; Zhu, L.H. Alternaria arborescens and A. italica Causing Leaf Blotch on Celtis julianae in China. Plants 2023, 12, 3113. [Google Scholar] [CrossRef]
- Woudenberg, J.H.C.; Groenewald, J.Z.; Binder, M.; Crous, P.W. Alternaria redefined. Stud. Mycol. 2013, 75, 171–212. [Google Scholar] [CrossRef]
- Qin, Q.M.; Fan, Y.Y.; Jia, Q.L.; Duan, S.S.; Liu, F.J.; Jia, B.X.; Wang, G.Q.; Guo, W.H.; Wang, C. The Potential of Alternaria Toxins Production by A. alternata in Processing Tomatoes. Toxins 2022, 14, 827. [Google Scholar] [CrossRef]
- Mitakakis, T.Z.; Barnes, C.; Tovey, E.R. Spore germination increases allergen release from Alternaria. J. Allergy Clin. Immunol. 2001, 107, 388–390. [Google Scholar] [CrossRef]
- Bush, R.K.; Prochnau, J.J. Alternaria-induced asthma. J. Allergy Clin. Immunol. 2004, 113, 227–234. [Google Scholar] [CrossRef]
- Pochon, S.; Terrasson, E.; Guillemette, T.; Iacomi-Vasilescu, B.; Georgeault, S.; Juchaux, M.; Berruyer, R.; Debeaujon, I.; Simoneau, P.; Campion, C. The Arabidopsis thaliana-Alternaria brassicicola pathosystem: A model interaction for investigating seed transmission of necrotrophic fungi. Plant Methods 2012, 8, 16. [Google Scholar] [CrossRef]
- Baez-Flores, M.E.; Troncoso-Rojas, R.; Osuna, M.A.I.; Dominguez, M.R.; Pryor, B.; Tiznado-Hernandez, M.E. Differentially expressed cDNAs in Alternaria alternata treated with 2-propenyl isothiocyanate. Microbiol. Res. 2011, 166, 566–577. [Google Scholar] [CrossRef]
- Timmer, L.W.; Peever, T.L.; Solel, Z.; Akimitsu, K. Alternaria diseases of citrus—Novel pathosystems. Phytopathol. Mediterr. 2003, 42, 1000–1014. [Google Scholar]
- Vicent, A.; Badal, J.; Asensi, M.J.; Sanz, N.; Armengol, J.; Garcia-Jimenez, J. Laboratory evaluation of citrus cultivars susceptibility and influence of fruit size on Fortune mandarin to infection by Alternaria alternata pv. citri. Eur. J. Plant Pathol. 2004, 110, 245–251. [Google Scholar] [CrossRef]
- Vega, B.; Dewdney, M.M. Distribution of Qol Resistance in Populations of Tangerine-Infecting Alternaria alternata in Florida. Plant Dis. 2014, 98, 67–76. [Google Scholar] [CrossRef] [PubMed]
- Vega, B.; Dewdney, M.M. Sensitivity of Alternaria alternata from Citrus to Boscalid and Polymorphism in Iron-Sulfur and in Anchored Membrane Subunits of Succinate Dehydrogenase. Plant Dis. 2015, 99, 231–239. [Google Scholar] [CrossRef]
- Song, J.H.; Wang, Y.F.; Yin, W.X.; Huang, J.B.; Luo, C.X. Effect of Chemical Seed Treatment on Rice False Smut Control in Field. Plant Dis. 2021, 105, 3218–3223. [Google Scholar] [CrossRef] [PubMed]
- Ju, Y.; Si, Y.Z.; Li, D.W.; Xu, W.; Sun, J.W.; Zhu, L.H. First Report of Leaf Blotch of Salix babylonica Caused by Botryosphaeria dothidea in China. Plant Dis. 2021, 105, 224. [Google Scholar] [CrossRef] [PubMed]
- Zhu, L.H.; Xu, W.; Huang, L.; Ye, J.R.; Li, D.W. Pathogenicity and Biological Characteristics of Septotinia populiperda Causing Leaf Blotch of Willow. Plant Dis. 2022, 106, 1262–1270. [Google Scholar] [CrossRef]
- Liao, Y.C.Z.; Wan, Y.; Si, Y.Z.; Geng, J.X.; Li, D.W.; Zhu, L.H. Leaf spot of Ligustrum japonicum caused by Diaporthe eres newly reported in China. Crop Prot. 2023, 164, 106139. [Google Scholar] [CrossRef]
- Si, Y.Z.; Sun, J.W.; Wan, Y.; Chen, Y.N.; He, J.; Li, W.Z.; Li, D.W.; Zhu, L.H. Neofusicoccum cryptomeriae sp. nov. and N. parvum Cause Stem Basal Canker of Cryptomeria japonica in China. J. Fungi 2023, 9, 404. [Google Scholar] [CrossRef]
- He, J.; Sun, M.-L.; Li, D.-W.; Zhu, L.-H.; Ye, J.-R.; Huang, L. A real-time PCR for detection of pathogens of anthracnose on Chinese fir using TaqMan probe targeting ApMat gene. Pest Manag. Sci. 2022, 79, 980–988. [Google Scholar] [CrossRef]
- White, T.J.; Bruns, T.D.; Lee, S.B.; Taylor, J.W. Amplification and direct sequencing of fungal ribosomal RNA genes for phylogenetics. In PCR Protocols: A Guide to Methods and Applications; University of New Mexico: Albuquerque, NM, USA, 1990; Volume 18, pp. 315–322. [Google Scholar]
- Carbone, I.; Kohn, L. A method for designing primer sets for speciation studies in filamentous ascomycetes. Mycologia 1999, 91, 553–556. [Google Scholar] [CrossRef]
- Berbee, M.L.; Pirseyedi, M.; Hubbard, S. Cochliobolus phylogenetics and the origin of known, highly virulent pathogens, inferred from ITS and glyceraldehydes-3-phosphate dehydrogenase gene sequences. Mycologia 1999, 91, 964–977. [Google Scholar] [CrossRef]
- Liu, Y.J.; Whelen, S.; Hall, B.D. Phylogenetic relationships among ascomycetes: Evidence from an RNA polymerse II subunit. Mol. Biol. Evol. 1999, 16, 1799–1808. [Google Scholar] [CrossRef] [PubMed]
- Hong, S.G.; Cramer, R.A.; Lawrence, C.B.; Pryor, B.M. Alt a 1 allergen homologs from Alternaria and related taxa: Analysis of phylogenetic content and secondary structure. Fungal Genet. Biol. 2005, 42, 119–129. [Google Scholar] [CrossRef] [PubMed]
- Katoh, K.; Standley, D.M. MAFFT multiple sequence alignment software version 7: Improvements in performance and usability. Mol. Biol. Evol. 2013, 30, 772–780. [Google Scholar] [CrossRef]
- Zhang, D.; Gao, F.; Jakovlic, I.; Zou, H.; Zhang, J.; Li, W.X.; Wang, G.T. PhyloSuite: An integrated and scalable desktop platform for streamlined molecular sequence data management and evolutionary phylogenetics studies. Mol. Ecol. Resour. 2020, 20, 348–355. [Google Scholar] [CrossRef] [PubMed]
- Li, J.-F.; Jiang, H.-B.; Jeewon, R.; Hongsanan, S.; Bhat, D.J.; Tang, S.-M.; Lumyong, S.; Mortimer, P.E.; Xu, J.-C.; Camporesi, E.; et al. Alternaria: Update on species limits, evolution, multi-locus phylogeny, and classification. Stud. Fungi 2023, 8, 1–61. [Google Scholar] [CrossRef]
- Zhang, Y.; Zhang, B.; Luo, C.; Fu, Y.; Zhu, F. Fungicidal Actions and Resistance Mechanisms of Prochloraz to Penicillium digitatum. Plant Dis. 2021, 105, 408–415. [Google Scholar] [CrossRef]
- Ypema, H.L.; Ypema, M.; Gubler, W.D. Sensitivity of Uncinula necator to Benomyl, Triadimefon, Myclobutanil, and Fenarimol in California. Plant Dis. 1997, 81, 293–297. [Google Scholar] [CrossRef] [PubMed]
- Gama, A.B.; Baggio, J.S.; Rebello, C.S.; Lourenco, S.d.A.; Gasparoto, M.C.d.G.; da Silva Junior, G.J.; Peres, N.A.; Amoriml, L. Sensitivity of Colletotrichum acutatum Isolates from Citrus to Carbendazim, Difenoconazole, Tebuconazole, and Trifloxystrobin. Plant Dis. 2020, 104, 1621–1628. [Google Scholar] [CrossRef]
- Han, S.; Lu, J.; Gao, J.; Cheng, J.; Xu, W.; Tao, L.; Zhang, Y. Pyraclostrobin induced AMPK/mTOR pathways mediated autophagy in RAW264.7 macrophages. J. Environ. Sci. Health Part B 2021, 56, 793–800. [Google Scholar] [CrossRef] [PubMed]
- Zhang, M.J.; Zheng, X.R.; Li, H.; Chen, F.M. Alternaria alternata, the Causal Agent of a New Needle Blight Disease on Pinus bungeana. J. Fungi 2023, 9, 71. [Google Scholar] [CrossRef]
- Meng, J.X.; Zhang, X.Y.; Han, X.S.; Fan, B. Application and Development of Biocontrol Agents in China. Pathogens 2022, 11, 1120. [Google Scholar] [CrossRef] [PubMed]
- Zhu, X.Q.; Xiao, C.L. Phylogenetic, Morphological, and Pathogenic Characterization of Alternaria Species Associated with Fruit Rot of Blueberry in California. Phytopathology 2015, 105, 1555–1567. [Google Scholar] [CrossRef]
- Romain, B.B.N.D.; Hassan, O.; Kim, J.S.; Chang, T. Alternaria koreana sp. nov., a new pathogen isolated from leaf spot of ovate-leaf Atractylodes in South Korea. Mol. Biol. Rep. 2022, 49, 413–420. [Google Scholar] [CrossRef] [PubMed]
- Ramirez-Villacis, D.; Barriga-Medina, N.; Llerena-Llerena, S.; Pazmino-Guevara, C.; Leon-Reyes, A. First Report of Alternaria alternata Causing Leaf Spot on Broccoli in Ecuador. Plant Dis. 2023, 107, 2866. [Google Scholar] [CrossRef]
- Sun, H.F.; Jiang, X.; Li, Z.; Wang, H.; Yan, Y.; Yang, H. First report of Alternaria alternata causing leaf blight on Trollius chinensis in China. Plant Dis. 2023, 107, 2533. [Google Scholar] [CrossRef]
- Pryor, B.M.; Michailides, T.J. Morphological, pathogenic, and molecular characterization of Alternaria isolates associated with Alternaria late blight of pistachio. Phytopathology 2002, 92, 406–416. [Google Scholar] [CrossRef]
- Lawrence, D.P.; Gannibal, P.B.; Peever, T.L.; Pryor, B.M. The sections of Alternaria: Formalizing species-group concepts. Mycologia 2013, 105, 530–546. [Google Scholar] [CrossRef]
- Woudenberg, J.H.C.; Truter, M.; Groenewald, J.Z.; Crous, P.W. Large-spored Alternaria pathogens in section Porri disentangled. Stud. Mycol. 2014, 79, 1–47. [Google Scholar] [CrossRef] [PubMed]
- Grum-Grzhimaylo, A.A.; Georgieva, M.L.; Bondarenko, S.A.; Debets, A.J.M.; Bilanenko, E.N. On the diversity of fungi from soda soils. Fungal Divers. 2016, 76, 27–74. [Google Scholar] [CrossRef]
- Ghafri, A.; Maharachchikumbura, S.S.N.; Hyde, K.D.; Al-Saady, N.; Al-Sadi, A.M. A new section and a new species of Alternaria encountered from Oman. Phytotaxa 2019, 405, 279–289. [Google Scholar] [CrossRef]
- Woudenberg, J.H.C.; Seidl, M.F.; Groenewald, J.Z.; de Vries, M.; Stielow, J.B.; Thomma, B.P.H.J.; Crous, P.W. Alternaria section Alternaria: Species, formae speciales or pathotypes? Stud. Mycol. 2015, 82, 1–21. [Google Scholar] [CrossRef] [PubMed]
- Giner, M.M.; Garcia, J.S.C.; Camacho, C.N. Airborne Alternaria spores in SE Spain (1993–98)—Occurrence patterns, relationship with weather variables and prediction models. Grana 2001, 40, 111–118. [Google Scholar] [CrossRef]
- Cabral, L.D.; Rodriguez, A.; Delgado, J.; Patriarca, A. Understanding the effect of postharvest tomato temperatures on two toxigenic Alternaria spp. strains: Growth, mycotoxins and cell-wall integrity-related gene expression. J. Sci. Food Agric. 2019, 99, 6689–6695. [Google Scholar] [CrossRef]
- Cao, X.M.; Li, Y.L.; Fan, J.L.; Zhao, Y.J.; Borriss, R.; Fan, B. Two Lysine Sites That Can Be Malonylated Are Important for LuxS Regulatory Roles in Bacillus velezensis. Microorganisms 2021, 9, 1338. [Google Scholar] [CrossRef]
- Gisi, U.; Sierotzki, H. Fungicide modes of action and resistance in downy mildews. Eur. J. Plant Pathol. 2008, 122, 157–167. [Google Scholar] [CrossRef]
- Stepanovic, M.; Vuksa, P.; Potocnik, I.; Milijasevic, S.; Rekanovic, E.; Todorovic, B. Integrated Management of Viral Sensitivity of Alternaria solani Isolates to Some Fungicides. In Proceedings of the II International Symposium on Tomato Diseases, Kusadasi, Turkey, 8–12 October 2007; pp. 377–380. [Google Scholar]
- Wang, F.; Saito, S.; Xiao, C.L. Fungicide Resistance of Alternaria alternata and A. arborescens Isolates from Mandarin Fruit and Its Influence on Control of Postharvest Alternaria Rot. Plant Dis. 2023, 107, 1538–1543. [Google Scholar] [CrossRef]

| Gene | Primer | Sequence (5′-3′) | PCR Amplification Cycle Parameters: |
|---|---|---|---|
| Internal transcribed spacer (ITS) | ITS1 ITS4 | TCCGTAGGTGAACCTGCGG TCCTCCGCTTATTGATATGC | 95 °C: 3 min, (95 °C: 30 s, 55 °C: 30 s, 72 °C: 35 s) × 32 cycles, 72 °C: 8 min |
| Elongation factor 1-alpha (TEF1-α) | EF1-728F EF1-986R | CATCGAGAAGTTCGAGAAGG TACTTGAAGGAACCCTTACC | 95 °C: 3 min, (95 °C: 30 s, 59 °C: 30 s, 72 °C: 20 s) × 32 cycles, 72 °C: 8 min |
| Glycerol-3-phosphate dehydrogenase (GAPDH) | GPD1 GPD2 | CAACGGCTTCGGTCGCATTG GCCAAGCAGTTG GTTGT | 94 °C: 3 min, (94 °C: 30 s, 59.5 °C: 30 s, 72 °C: 40 s) × 32 cycles, 72 °C: 8 min |
| RNA polymerase second-largest subunit (RPB2) | RPB2-5F2 RPB2-7cR | GGGGWGAYCAGAAGAAGGC CCCATRGCTTGTYYRCCCAT | 94 °C: 3 min, (94 °C: 30 s, 53 °C: 30 s, 72 °C: 50 s) × 32 cycles, 72 °C: 8 min |
| Alternaria major allergen gene (Alt a 1) | Alt-al-for Alt-al-rev | ATGCAGTTCACCACCATCGC ACGAGGGTGAYGTAGGCGTC | 95 °C: 3 min, (95 °C: 30 s, 60.5 °C: 30 s, 72 °C: 30 s) × 32 cycles, 72 °C: 8 min |
| Species | Isolate | Accession Numbers | ||||
|---|---|---|---|---|---|---|
| ITS | GAPDH | TEF1-α | RPB2 | Alt a 1 | ||
| Alternaria alstroemeriae | CBS 118809 T | KP124297 | KP124154 | KP125072 | KP124765 | KP123845 |
| Alternaria sp. | CBS 108.27 | KC584236 | KC584162 | KC584727 | KC584468 | - |
| A. alternantherae | CBS 124392 | KC584179 | KC584096 | KC584633 | KC584374 | KP123846 |
| A. alternata | CBS 916.96 T | AF347031 | AY278808 | KC584634 | KC584375 | AY563301 |
| A. arborescens | CBS 102605 T | AY347033 | AY278810 | KC584636 | KC584377 | AY563303 |
| A. alternata | 11 | OP476716 | OP609771 | OP609768 | OP604538 | OP609775 |
| A. alternata | 13 | OP476718 | OP609773 | OP609770 | OP604540 | OP609776 |
| A. arctoseptata | MFLUCC 21-0139 T | - | OK236702 | 0K236608 | OK236655 | OK236755 |
| A. baoshanensis | MFLUCC 21-0124 T | MZ622003 | OK236706 | OK236613 | OK236659 | OK236760 |
| A. betae-kenyensis | CBS 118810 T | KP124419 | KP124270 | KP125197 | KP124888 | KP123966 |
| A. breviconidiophora | MFLUCC 22-0075 T | MZ621997 | OK236698 | OK236604 | OK236651 | - |
| A. burnsii | CBS 107.38 T | KP124420 | JQ646305 | KP125198 | KP124889 | KP123967 |
| A. brassicicola | AC71 | LC440588 | LC482009 | LC480214 | LC476794 | LC481621 |
| A. doliconidium | KUN-HKAS 100840 T | NR158361 | - | - | - | - |
| A. ellipsoidialis | MFLUCC 21-0132 T | MZ621989 | OK236690 | OK236596 | OK236643 | OK236743 |
| A. eupatoriicola | MFLUCC 21-0122 T | MZ621982 | OK236683 | OK236589 | OK236636 | OK236736 |
| A. eichhorniae | CBS 489.92 T | KC146356 | KP124276 | KP125204 | KP124895 | KP123973 |
| A. eichhorniae | CBS 119778 | KP124426 | KP124277 | KP125205 | KP124896 | KP123973 |
| A. falcata | MFLUCC 21-0123 T | MZ621992 | OK236693 | OK236599 | OK236646 | OK236746 |
| A. gaisen | CBS 632.93 | KC584197 | KC584116 | KC584658 | KC584399 | KP123974 |
| A. gaisen | CBS 118488 | KP124427 | KP124278 | KP125206 | KP124897 | KP123975 |
| A. gossypina | CBS 104.32 T | KP124430 | JQ646312 | KP125209 | KP124900 | JQ646395 |
| A. gossypina | CBS 107.36 T | KP124431 | JQ646310 | KP125210 | KP124901 | JQ646393 |
| A. iridiaustralis | CBS 118404 | KP124434 | KP124283 | KP125213 | KP124904 | KP123980 |
| A. iridiaustralis | CBS 118486 T | KP124435 | KP124284 | KP125214 | KP124905 | KP123981 |
| A. jacinthicola | CBS 878.95 | KP124437 | KP124286 | KP125216 | KP124907 | KP123983 |
| A. jacinthicola | CBS 133751 T | KP124438 | KP124287 | KP125217 | KP124908 | KP123984 |
| A. koreana | SPL2-1 (KACC49833) T | LC621613 | LC621647 | LC621715 | LC621681 | LC631831 |
| A. koreana | SPL2-4 | LC621615 | LC621649 | LC621717 | LC621683 | LC631832 |
| A. koreana | 12 | OP476717 | OP609772 | OP609769 | OP604539 | OP609774 |
| A. lathyri | MFLUCC 21-0140 T | MZ621974 | OK236675 | OK236581 | OK236628 | OK236728 |
| A. longipes | CBS 539.94 | KP124441 | KP124290 | KP125220 | KP124911 | KP123987 |
| A. longipes | CBS 540.94 | AY278835 | AY278811 | KC584667 | KC584409 | AY563304 |
| A. macroconidia | MFLUCC 21-0134 T | MZ622001 | OK236704 | OK236610 | OK236657 | OK236757 |
| A. minimispora | MFLUCC 21-0127 T | MZ621980 | OK236681 | OK236587 | OK236634 | OK236734 |
| A. muriformispora | MFLUCC 22-0073 T | MZ621976 | OK236677 | OK236583 | OK236630 | OK236730 |
| A. ovoidea | MFLUCC 14-0427 T | MZ622005 | OK236708 | OK236614 | OK236661 | OK236761 |
| A. oblongoellipsoidea | MFLUCC 22-0074 T | MZ621967 | OK236668 | OK236574 | OK236621 | OK236721 |
| A. obpyriconidia | MFLUCC 21-0121 T | MZ621978 | OK236680 | OK236585 | OOK236633 | OK236732 |
| A. phragmiticola | MFLUCC 21-0125 T | MZ621994 | OK236696 | OK236602 | OK236649 | OK236749 |
| A. pseudoinfectoria | MFLUCC 21-0126 T | MZ621984 | OK236685 | OK236591 | OK236638 | OK236738 |
| A. rostroconidia | MFLUCC 21-0136 T | MZ621969 | OK236670 | OK236576 | OK236623 | OK236723 |
| A. salicicola | MFLUCC 22-0072 T | MZ621999 | OK236700 | OK236606 | OK236653 | OK236753 |
| A. setosa | YZU 191101 T | OP341770 | OP352306 | OP374459 | OP352294 | OP293717 |
| A. solani | CBS 103.30 | KC584217 | KC584139 | KC584688 | KC584430 | GQ180097 |
| A. tectorum | YZU 161050 T | OP341728 | OP352303 | OP374456 | OP352291 | OP293714 |
| A. tectorum | YZU 161052 | OP341817 | OP352304 | OP374457 | OP352292 | OP293715 |
| A. tomato | CBS 103.30 | KP124445 | KP124294 | KP125224 | KP124915 | KP123991 |
| A. tomato | CBS 114.35 | KP124446 | KP124295 | KP125225 | KP124916 | KP123992 |
| A. torilis | MFLUCC 14-0433 T | MZ621988 | OK236688 | OK236594 | OK236641 | OK236741 |
| A. vitis | MFLUCC 17-1109 T | MG764007 | - | - | - | - |
| Fungicide | EC50 Values (µg/mL) | ||
|---|---|---|---|
| 11 | 12 | 13 | |
| Prochloraz | 2.95 ± 0.31 d | 3.96 ± 0.4 c | 4.05 ± 0.42 d |
| Myclobutanil | 84.41 ± 3.33 a | 55.14 ± 2.34 a | 87.89 ± 3.73 c |
| Tebuconazole | 35.32 ± 5.98 c | 13.96 ± 2.52 c | 143.17 ± 8.93 b |
| Pyraclostrobin | 50.53 ± 2.05 b | 34.5 ± 7.66 b | 422.26 ± 27.69 a |
Disclaimer/Publisher’s Note: The statements, opinions and data contained in all publications are solely those of the individual author(s) and contributor(s) and not of MDPI and/or the editor(s). MDPI and/or the editor(s) disclaim responsibility for any injury to people or property resulting from any ideas, methods, instructions or products referred to in the content. |
© 2023 by the authors. Licensee MDPI, Basel, Switzerland. This article is an open access article distributed under the terms and conditions of the Creative Commons Attribution (CC BY) license (https://creativecommons.org/licenses/by/4.0/).
Share and Cite
Wang, Q.; Zhang, X.; Wan, Y.; Zhao, Y. Alternaria alternata and Alternaria koreana, the Causal Agents of Leaf Spot in Celtis sinensis and Their Sensitivity to Fungicides. Forests 2023, 14, 2389. https://doi.org/10.3390/f14122389
Wang Q, Zhang X, Wan Y, Zhao Y. Alternaria alternata and Alternaria koreana, the Causal Agents of Leaf Spot in Celtis sinensis and Their Sensitivity to Fungicides. Forests. 2023; 14(12):2389. https://doi.org/10.3390/f14122389
Chicago/Turabian StyleWang, Qiuqin, Xiuyu Zhang, Yu Wan, and Yinjuan Zhao. 2023. "Alternaria alternata and Alternaria koreana, the Causal Agents of Leaf Spot in Celtis sinensis and Their Sensitivity to Fungicides" Forests 14, no. 12: 2389. https://doi.org/10.3390/f14122389
APA StyleWang, Q., Zhang, X., Wan, Y., & Zhao, Y. (2023). Alternaria alternata and Alternaria koreana, the Causal Agents of Leaf Spot in Celtis sinensis and Their Sensitivity to Fungicides. Forests, 14(12), 2389. https://doi.org/10.3390/f14122389

